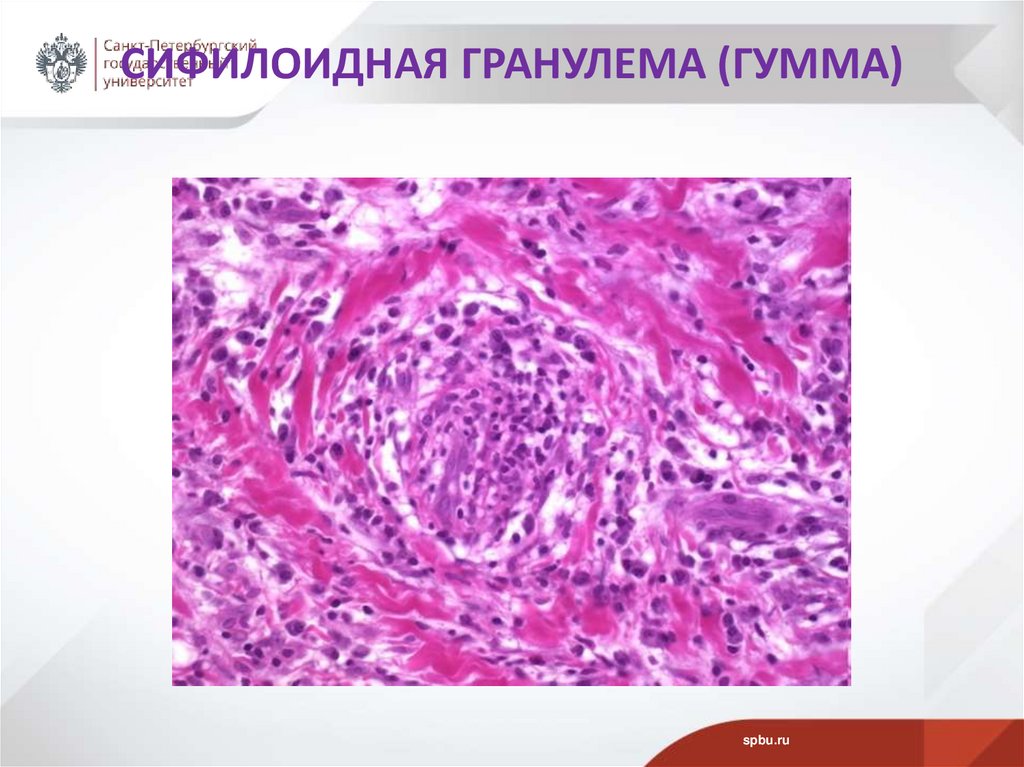
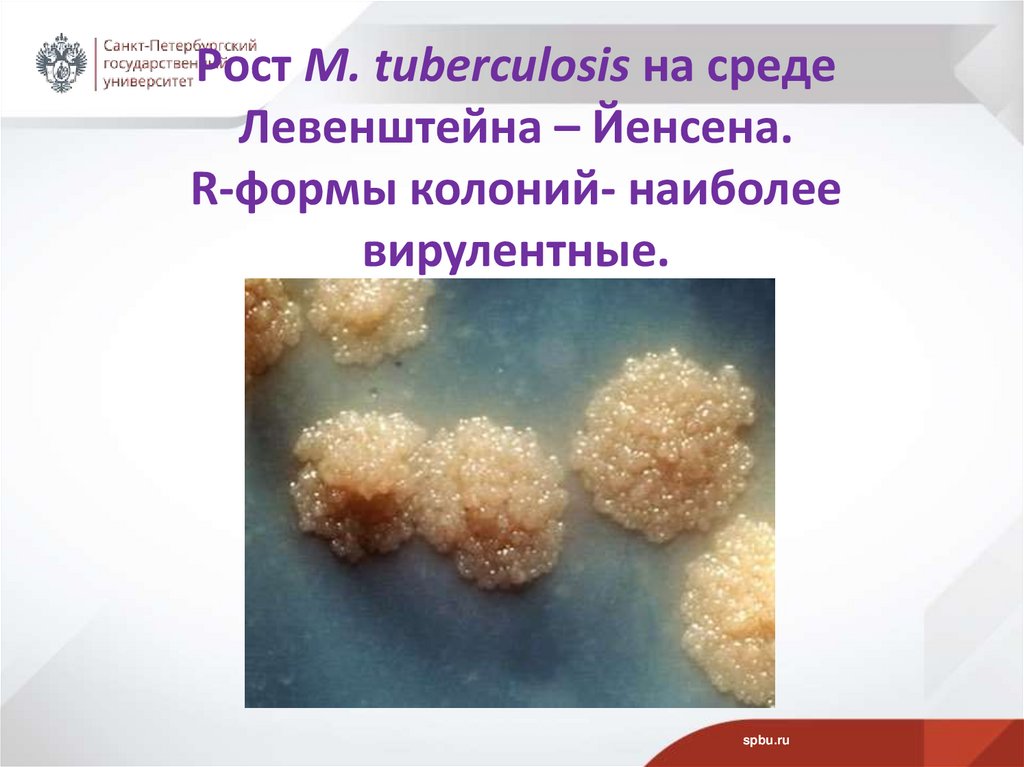

Similar presentations:
Возбудители туберкулеза
1. Возбудители туберкулеза
ВОЗБУДИТЕЛИ ТУБЕРКУЛЕЗАд.б.н.,проф.
Рыбальченко О.В.
СПбГУ, 27.03.2025
2. План
• 1. Возбудители туберкулеза. Заболеваемость туберкулезом.• 2. Роберт Кох - определение этиологической значимости микобактерий.
Противотуберкулезная вакцина БЦЖ.
• 3. Локализация туберкулезного процесса и клиническая картина
заболевания человека. Туберкулез у животных.
• 4. Пути заражения туберкулезом. Туберкулезная гранулема.
• 5. Таксономия р. Mycobacterium. Нетуберкулезные микобактерии.
• 6. Морфологические свойства МБ. Окраска по Цилю-Нильсену.
Особенности строения клеточной стенки МБ. Особые тинкториальные
свойства МБ.
• 7. Устойчивость МБТ к факторам внешней среды. Культуральные
свойства.
• 8. Факторы патогенности M. tuberculosis. Взаимодействие макрофагов с
микобактериями.
• 9. Антигенные свойства МБТ. Специфические белки M. tuberculosis.
Кожно-аллергические реакции: Пирке и Манту.
• 10. Чувствительность МБ к ПТП и АМП.
spbu.ru
3. ВОЗБУДИТЕЛИ ТУБЕРКУЛЕЗА (tuberculum лат. – бугорок)
Род Mycobacterium1. вид M. tuberculosis (человек)
2. вид M. tuberculosis variant
(животные) - ранее вид М. bovis
spbu.ru
bovis
4. ТУБЕРКУЛЕЗ
• Инфекционное заболевание человека и животных,вызываемое туберкулезными микобактериями (ТМБ)
• M. tuberculosis и M. tuberculosis variant bovis
• с характерным поражением различных систем и органов
- гранулем.
spbu.ru
5. ТУБЕРКУЛЕЗНЫЙ ПРОЦЕСС
Может происходитьне только в легких,
но и в почках,
костях,
суставах,
коже,
мозговой
оболочке.
spbu.ru
6. ПОРАЖЕННЫЕ МИКОБАКТЕРИЯМИ ЛЕГКИЕ
spbu.ru7. РЕНТГЕНОГРАММА ЛЕГКИХ ПРИ ТУБЕРКУЛЕЗЕ
spbu.ru8. КЛИНИЧЕСКАЯ КАРТИНА ТУБЕРКУЛЕЗА КОЖИ
spbu.ru9. ГИСТОЛОГИЧЕСКИЙ СРЕЗ ТУБЕРКУЛЕЗНОЙ ГРАНУЛЕМЫ
spbu.ru10. ГРАНУЛЕМЫ СПЕЦИФИЧЕСКИЕ И НЕСПЕЦИФИЧЕСКИЕ
Специфические гранулемы - характерны дляопределенного инфекционного заболевания, их
возбудителей можно найти в клетках гранулемы при
гистобактериоскопическом исследовании (гранулемы при
туберкулезе, сифилисе, саркоидозе, лепре и склероме).
Неспецифические гранулемы не имеют характерных черт,
присущих специфическим гранулемам. Они встречаются
при ряде инфекционных (сыпнотифозная и
брюшнотифозная гранулемы) и неинфекционных
заболеваний (гранулемы при силикозе и асбестозе,
гранулемы инородных тел).
spbu.ru
11. СИФИЛОИДНАЯ ГРАНУЛЕМА (ГУММА)
spbu.ru12. ТУБЕРКУЛЕЗНАЯ ГРАНУЛЕМА СТРОЕНИЕ
• В центре - очаг некроза, по периферии — слой изэпителиоидных клеток и лимфоцитов с примесью
макрофагов и плазматических клеток.
• Между эпителиоидными клетками и лимфоцитами гигантские клетки Пирогова — Лангханса - типичные для
туберкулезной гранулемы.
• При импрегнации солями серебра среди клеток
гранулемы обнаруживается сеть аргирофильных волокон.
Небольшое
число
кровеносных
капилляров
обнаруживается только в наружных зонах бугорка.
• При окраске по Цилю—Нильсену в гигантских клетках
Пирогова—Лангханса–
красные
микобактерии
туберкулеза.
spbu.ru
13. СТРУКТУРА ТУБЕРКУЛЕЗНОЙ ГРАНУЛЕМЫ
spbu.ru14. Эпителиоидные клетки
• Еpithelioid cell - клетки, обнаруживаемые вне эпителия,но обладающие рядом характеристик эпителиальных
клеток
spbu.ru
15. ФОРМИРОВАНИЕ СПЕЦИФИЧЕСКОЙ ГРАНУЛЕМЫ
TGFb (трансформирующий ростовой фактор-бета, ТРФ-бета). Члены этогосемейства влияют на множество типов клеток, участвуют в регуляции их
роста, дифференцировке и апоптозе, а также в модуляции иммунной
системы.
spbu.ru
16. Генрих Герман Роберт Кох немецкий микробиолог (1843 – 1910)
Лауреат Нобелевской премиипо физиологии и медицине
1905 г. за определение
этиологической значимости
бактерий:
1. Бацилла сибирской язвы 1876.
2. Холерный вибрион -1883 г.
3.Туберкулезная
палочкапалочка Коха - 1882 г.
spbu.ru
17. УСПЕХИ и Неудачи в лечении туберкулеза
УСПЕХИ И НЕУДАЧИВ ЛЕЧЕНИИ ТУБЕРКУЛЕЗА
Туберкулез входит в десятку основных причин смертности.
В мире ок. 10 млн человек болеют туберкулезом.
В год умирают более 1,2 млн пациентов (данные ВОЗ).
• Положительные результаты в лечении туберкулеза стали
отмечать около 70-60 лет назад.
• 1. Прививка БЦЖ (BCG)
• 2. Создание противотуберкулезных
• препаратов (ПТП)
В настоящее время при массовой
инфицированности прививка
БЦЖ не обеспечивает полной защиты!!!
spbu.ru
18. ПРОТИВОТУБЕРКУЛЕЗНАЯ ВАКЦИНА БЦЖ
БЦЖ - BCG• Bacilla
• Calmette
• Guerin
• БЦЖ - транслитерация французской
аббревиатуры BCG
БЦЖ - живая аттенуированная ослабленная
культура M. bovis
spbu.ru
19. СОЗДАТЕЛИ ВАКЦИНЫ BCG (БЦЖ)
Альберт КальметтС. Guerin (1872- 1961)
Камиль Герен
(1863 г. – 1933 г.)
А.Calmette
spbu.ru
20. ВАКЦИНИРОВАНИЕ БЦЖ (BCG) НОВОРОЖДЕННЫХ
• На 3-7-е сутки в родильных домах всехноворожденных вакцинируют БЦЖ-М.
• Если в окружении новорожденных туберкулезные больные или показатель
заболеваемости в данной географической зоне
превышает 80 на 100 тыс. населения, то
применяют вакцину БЦЖ.
spbu.ru
21. ЗАБОЛЕВАЕМОСТЬ ТУБЕРКУЛЕЗОМ ДЕТЕЙ 0-14 ЛЕТ В СПБ В 2020-2021 ГГ.
В 2021 г. - 4,7 на 100 тыс. детского населения,эти показатели на 7,8% ниже, чем в 2020 г.,
и на 25,3 % ниже заболеваемости по РФ.
spbu.ru
22. СНИЖЕНИЕ ЗАБОЛЕВАЕМОСТИ ТУБЕРКУЛЕЗОМ В РФ (данные Роспотребнадзор)
• С 2007 года началось снижениезаболеваемости туберкулезом.
• Число умерших от туберкулеза снизилось
более, чем в 4 раза (с 29 966 человек в 2019
г. до 7 264 человек в 2020 г.).
spbu.ru
23. СНИЖЕНИЕ СМЕРТНОСТИ В РФ от туберкулеза на 100 тыс. населения
spbu.ru24. ЗАБОЛЕВАЕМОСТЬ ТУБЕРКУЛЕЗОМ В СПБ
Мигранты - 47% заболеваемости.Дети мигрантов - 34,1% заболеваемости.
Подростки мигрантов - 64% заболеваемости.
spbu.ru
25. ЗАБОЛЕВАЕМОСТЬ ТУБЕРКУЛЕЗОМ В РФ В РАЗЛИЧНЫХ СОЦИАЛЬНЫХ ГРУППАХ
• От общего числа заболевших (%)• работающих граждан -27,7
• неработающих граждан -52,8
• школьников - 2,5
• студентов - 2,4
• дошкольников - 1,6
• инвалидов - 5,4
• пенсионеров - 7,6
spbu.ru
26. НЕОДНОЗНАЧНОСТЬ СИТУАЦИИ С ЗАБОЛЕВАНИЕМ ТУБЕРКУЛЕЗОМ В РФ
С каждым годом регистрируют все меньше случаев,уровень смертности среди больных продолжает падать уже
более 10 лет.
Однако общее число россиян, страдающих от туберкулеза,
все еще очень высокое.
Болезнь все хуже поддается лечению, а выздоравливают
лишь две трети пациентов.
Несмотря на существенный прогресс в этой сфере, РФ попрежнему входит в число стран,
где ситуация с туберкулезом
остается сложной.
spbu.ru
27. ТУБЕРКУЛЕЗ 4 ОСНОВНЫЕ ПРОБЛЕМЫ В РФ (данные ВОЗ)
1. Высокий уровень заболеваемости туберкулезом смножественной лекарственной устойчивостью.
2. Дефицит лекарств второй линии (препараты
повышенной токсичности для лечения тяжелых форм
туберкулеза).
3. Слабый контроль за инфекцией в
противотуберкулезных учреждениях.
4. Нехватка врачей-фтизиатров.
При массовой инфицированности прививка БЦЖ не
обеспечивает полной защиты!!!
.
spbu.ru
28. СПЕКТР КЛИНИЧЕСКИХ ПРОЯВЛЕНИЙ ТУБЕРКУЛЕЗА
• Спектр проявлений очень широк:• малозаметные проявления с неспецифической
интоксикацией,
• опасные для жизни формы заболевания с
• вполне конкретными органными нарушениями,
• острые скоротечные симптомы и хронические
патологические процессы.
spbu.ru
29. ТУБЕРКУЛЕЗ У ЖИВОТНЫХ
• Лабораторные животные практически всевосприимчивы к туберкулезу.
• В естественных условиях болеют:
человекообразные обезьяны,
крупный рогатый скот,
свиньи.
spbu.ru
30. ПУТИ ЗАРАЖЕНИЯ ТУБЕРКУЛЕЗОМ
1.2.
3.
95-96% - аэрогенный путь
3% алиментарный путь
1% контактный путь - контакт с инфицированными
животными
spbu.ru
31. ИНФИЦИРОВАНИЕ ТУБЕРКУЛЕЗНЫМИ МИКОБАКТЕРИЯМИ (ТМБ)
Одна треть населения Земного Шара –инфицировано ТМБ.
Только у 10% инфицированных лиц- клинические
проявления.
Это свидетельствует о существовании мощных
механизмов резистентности.
Развитие туберкулеза зависит от:
чувствительности организма человека,
особенностей МБТ-устойчивости к ПТП.
spbu.ru
32. Факторы, способствующие развитиЮ туберкулеза
ФАКТОРЫ, СПОСОБСТВУЮЩИЕ РАЗВИТИЮТУБЕРКУЛЕЗА
Для развития туберкулеза важно общее состояние
здоровья человека!!!
У детей и взрослых провоцирующая роль инфекционные заболевания:
У детей - корь и коклюш.
Влияют эндогенные факторы:
диабет, белковое голодание,
последствия лечения кортикостероидами,
психические заболевания, алкоголизм, депрессия.
Т.обр., туберкулез провоцируют все заболевания,
снижающие резистентность организма!!!
spbu.ru
33. ГИПОРЕЗИСТЕНТНОСТЬ К МБ
• У лиц с избирательными иммунодефицитами:напр., с врожденным дефектом по Th1-хелперам,
цитокинам и их рецепторам (γ-интерферон,
интерлейкин 12).
spbu.ru
34. ЦЕНТРАЛЬНАЯ РОЛЬ В ПРОТИВОТУБЕРКУЛЕЗНОМ ИММУНИТЕТЕ
• принадлежит Т-хелперам, опосредующимформирование опсонизирующих АТ, активацию
макрофагов и цитотоксичность естественных
киллеров.
spbu.ru
35. Таксономия р. Mycobacterium более 60 видов
МБТ туберкулеза:М. tuberculosis (у человека)
M. tuberculosis variant bovis (у
животных)
• Нетуберкулезные микобактерии (НТМБ)
• Ранее абсолютными сапрофитами считали:
• M.avium
• M.intracellulare
• Совр. такс.: M.avium complex (MAC)
• M.asiaticum
• M. gordonae и т.д.
spbu.ru
36. НТМБ ВЫЗЫВАЮТ МИКОБАКТЕРИОЗЫ
Наиболее часто встречаемые НТМБ вклинических образцах:
M. ulcerans
M. tuberculosis variant africanum
M.kansasii
M.xenopi
M. haemophilum
spbu.ru
37.
Нормальная микробиотаM. smegmatis
Туберкулез
Микобактериозы
2%
M. tuberculosis
M. bovis
98%
Микобактерии
Лепра
M. leprae
Объекты окружающей
среды (ООС)
spbu.ru
38. МБ ОБЪЕДИНЕНЫ В род Mycobacterium
На основе общего свойства:наличие миколовых кислот (40-60%) в клеточной стенке,
что обеспечивает их:
• кислото-,
• щелоче-,
• спиртоустойчивость.
• Миколовые кислоты —длинноцепочечные
разветвлённые жирные кислоты:
• - R1-CHOH-CHR2-COOH - с перекрестными
сшивками, по 60-90 атомов углерода в молекуле
(С60-С90).
spbu.ru
39. СХЕМА СТРОЕНИЯ КЛЕТОЧНОЙ СТЕНКИ МБ
spbu.ru40. МОРФОЛОГИЧЕСКИЕ СВОЙСТВА МБ
• Гр+ палочки, но не окрашиваются по Граму• Тонкие, прямые и изогнутые
• Длина – от 1 до 4 мкм
• Ширина – 0,3-0,4 мкм
spbu.ru
41. ОСОБЫЕ ТИНКТОРИАЛЬНЫЕ СВОЙСТВА МБ плохо окрашиваются анилиновыми красителями. Для окрашивания используют метод Циля-Нильсена МБ
– красного цветаspbu.ru
42. МЕТОД ОКРАСКИ Циля-Нильсена
Основнойкраситель
Карболовый
фуксин Циля
3-5 мин при
нагревании
Дифференцирующе
е вещество
Раствор серной
кислоты
1-2 мин
Промывка
Вода
5-10 сек
Дополнительный
краситель
Метиленовый
синий
3-5 мин
Промывка
Вода
5-10 сек
spbu.ru
43. Клетки M. tuberculosis в мокроте (окраска по Цилю-Нильсену)
spbu.ru44. КУЛЬТУРАЛЬНЫЕ СВОЙСТВА МБ Аэробные бактерии (O/F – тест +/-) Опт. Т°- 37°С МБ отличаются по скорости роста
spbu.ru45. ПИТАТЕЛЬНЫЕ СРЕДЫ ДЛЯ МБ
• Требуют сложных по составу сред:• Среда Левенштейна - Йенсена (яичный
желток с картофельной мукой, глицерином
и солями).
spbu.ru
46. СИНТЕТИЧЕСКАЯ СРЕДА Сотона
аспарагин, глицерин, цитрат железа, фосфат калияНа ППС – через 4-6 недель морщинистые колонии с
неровными краями.
В ЖПС – нежная пленка на поверхности,
утолщаясь, падает на дно.
spbu.ru
47. Рост M. tuberculosis на среде Левенштейна – Йенсена. R-формы колоний- наиболее вирулентные.
spbu.ru48. Рост M. tuberculosis (a) M. bovis (б) в глицериновом бульоне
spbu.ru49. УСКОРЕННАЯ ИДЕНТИФИКАЦИЯ - МЕТОД Прайса
Клетки патогенных МБ располагаются в виде жгутов-нитей(от англ. сord-жгут, веревка).
Нити – свидетельство наличия корд-фактора, Cordгликолипида (трегалоза-6,6-димиколят).
Световая микроскопия
культуры, содержащей
корд-фактор (Cord+) клетки
M. tuberculosis
spbu.ru
50. Устойчивость МБТ к факторам внешней среды
Очень устойчивы:в пыли – до 3-х мес.
в воде – до 5 мес.
почве – до 6 мес.
Солнечный свет приводит к гибели через 1 час.
Антисептики – действуют медленно (фенол › 24
час).
Многие антисептики не эффективны.
spbu.ru
51. БИОХИМИЧЕСКИЕ СВОЙСТВА
• Некоторые признаки МБ вместе скультуральными особенностями используют для
дифференцирования видов МБ.
• 1. ниациновый тест + (происходит накопление
никотиновой кислоты)
• 2. редукция нитратов в нитриты.
spbu.ru
52. Факторы патогенности M. tuberculosis
• Не образуют экзотоксины!!!• Специфичность действия патогенных факторов
выражена в образовании гранулем и поражении
тканей.
• Поражение тканей происходит за счет липидов:
1. воск Д,
2. жирные кислоты: миколовая, миколиновая,
фтиоидная, туберкулостеариновая,
3. корд-фактор (трегалоза-6,6-димиколят),
4. сульфатиды,
5. фосфатиды.
spbu.ru
53. ТОКСИЧЕСКОЕ ДЕЙСТВИЕ корд-фактора
Вызывает: нарушение метаболических процессов вэукариотических клетках.
Нарушает дыхательную функцию в клетках
эукариот, блокируя окислительное
фосфорилирование в митохондриях макрофагов.
МБ могут даже размножаться в
Макрофагах!!!
spbu.ru
54. Взаимодействие макрофагов с микобактериями
12
Фагоцитоз
Препятствие слияния защелачивание фагосомы
аммонием.
Выход из фагосомы путем
разрыва мембраны
(сульфатиды и корд-фактормембранотропны).
В фагосомах гликолипиды
сглаживают биоцидное
действие каталазы и
пероксидазы.
Смысл – конкуренция МБ с макрофагами за железо.
Тандем сидерофоров: экзохелины-пептиды и микобактины - липиды.
Экзохелины извлекают ионы железа из микроокружения и передают
микобактинам (липиды клеточной стенки) - обеспечивают накопление и
spbu.ru
транспорт железа внутрь МБ.
55. Антигенные свойства МБ
АГ-протеиновый комплекс- ТУБЕРКУЛИН
Кожно-аллергические реакции:
Пирке и Манту
spbu.ru
56. Кожно-аллергическая реакция Пирке
• Служит для выявления первичного заражения детей.• Туберкулин наносят на кожу и через каплю производят
неглубокие кожные насечки.
spbu.ru
57. Кожно-аллергическая реакция Манту
• Для отбора подлежащих ревакцинации лиц туберкулинвводят внутрикожно, что вызывает у инфицированных
МБ лиц местную воспалительную реакцию в виде
инфильтрата и покраснения.
spbu.ru
58. Реакция Манту
spbu.ru59. Реакция Манту Оценивают результат через 72 час
spbu.ru60. Реакция Манту Измерять нужно только уплотнение!!!
spbu.ru61. РЕАКЦИЯ Манту
spbu.ru62. Реакция Манту Отрицательная реакция: 0-1 мм Сомнительная реакция: 2-4 мм Положительная реакция: 5 мм и более, Слабо
положительная: 5-9 мм,Средней интенсивности: 10-14 мм,
Выраженная: 15-16 мм
spbu.ru
63. ИММУНОЛОГИЧЕСКИЕ МЕТОДЫ
• Диагностический тест T-spot test (c 2001г.) основанна стимуляции Т-клеток специфическими АГ белками ESAT-6 и CFP-10 M. tuberculosis на
продуцирование INF-γ.
• Квантифероновый тест QuantiFERON-TB Gold
• (с 2005г.) основан на количественном определении
интерферона INF-γ, высвобождаемого
сенсибилизированными Т-клетками,
стимулированными in vitro специфическими АГ
(ESAT-6, CFP-10, RD1) M.tuberculosis
• Введен в обязательный комплекс фтизиатрического
обследования в 78 странах мира.
spbu.ru
64. СПЕЦИФИЧЕСКИЕ БЕЛКИ M. tuberculosis
ESAT6 (7 пептидов) - early secretory antigenic target protein 6М.tuberculosis.
CFP10 (6 пептидов)- culture filtrate protein 10 М.tuberculosis.
Оба белка зашифрованы в пределах, т.н. «1-ой зоны
специфичности» region of difference 1 (RD1) генома
М.tuberculosis.
Этих белков нет в клетках M. bovis и в клетках вакцинных
штаммов БЦЖ, полученных из них.
Этих белков также нет в других многих МБ, кроме
M.kansasii, M.marinum и М. szulgai.
spbu.ru
65. ДИАСКИН -ТЕСТ
Diaskintest® (с 2009 г.)Аналог туберкулиновой пробы (реакция Манту).
Аллерген туберкулезный рекомбинантный, действие основано
на реакции гиперчувствительности замедленного типа к
аллергену.
Аллерген - два белка, соединенных вместе (ESAT6/CFP10), синтез
которых кодируется в уникальной, отличной от других
микобактерий, части генома M. tuberculosis.
ПРОТИВОПОКАЗАНИЯ!!!!!!!!!
У лиц на ранних стадиях туберкулезного процесса, у больных с тяжелым
течением туберкулеза, а также с сопутствующими заболеваниями (СПИД,
вирусные гепатиты и др.) реакция на пробу с препаратом ДИАСКИНТЕСТ®
может быть отрицательной.
В отличие от реакции замедленного типа, кожные проявления
неспецифической аллергии (в основном гиперемия) на препарат, как правило,
наблюдаются сразу после постановки пробы и через 48-72 ч обычно исчезают.
spbu.ru
66. ФУНДАМЕНТАЛЬНЫЕ ИССЛЕДОВАНИЯ МБ Белок MPT64
Предоминантный белок MPT64, М.м. 24 kDa, обладаетиммуногенными свойствами.
MPT64 состоит из 33 специфических белков, отличается
тем, что секретируется во внешнюю среду, являясь
индикатором роста М.tuberculosis.
Предложен как потенциальный кандидат
вакцины, распознается T-лимфоцитами CD4+.
spbu.ru
в
состав
67. Диагностика туберкулеза
1.Микроскопия:Люминесцентная (флюорохромом аурамином)
Световая (метод Прайса)
Окраска по Цилю-Нильсену
2.Культуральные методы:
выращивание 3 недели и более
чувствительность к ПТП
3. Кожно-аллергические пробы (Пирке и Манту)
4. Молекулярно-биологические исследования: ПЦР
5. Неспецифические тесты:
Газожидкостная хроматография (на миколовые кислоты)
spbu.ru
68. ИММУНИТЕТ ПРИ ПОПАДАНИИ МБ В ОРГАНИЗМ ЧЕЛОВЕКА
ИММУНИТЕТ формируется после вакцинации БЦЖ или призаражении МБ.
Обусловлен длительной персистенцией L-форм МБ.
Решающая роль принадлежит клеточному иммунитету.
Исход заболевания определяется активностью Т-хелперов,
которые активируют фагоцитарную активность макрофагов
и активность Т-киллеров.
spbu.ru
69. ЧУВСТВИТЕЛЬНОСТЬ МБ к ПТП и АМП
1. Стрептомицин (блокирование синтеза белка наэтапе элонгации)
2. Гидразид изоникотиновой кислоты (ГИНК)
тубазид, фтивазид, изоницид, (блокирование
синтеза миколовых кислот)
3. Парааминосалициловая кислота (ПАСК)
(нарушение синтеза фолиевой кислоты)
Препараты второго ряда:
Циклосерин (ингибитор синтеза пептидогликана)
Рифампицин (блокирование транскрипции)
spbu.ru
70. ПРОТИВОТУБЕРКУЛЁЗНЫЕ ПРЕПАРАТЫ
ГруппаНазвание
Механизм действия
Аминогликозиды
Стрептомицин,
гентамицин
Блок синтеза белка на этапе
элонгации
циклосерины
циклосерин
Ингибитор синтеза
пептидогликана
ГИНК
тубазид,
фтивазид
Блок синтеза миколовой
кислоты
ПАСК
ПАСК
Нарушение синтеза фолиевой
кислоты
рифампицины
рифампицин
Блок транскрипции
фторхинолоны
ципрофлоксаци
н
Блок ДНК-гиразы
этамбутол
этамбутол
Блок синтеза компонентов
клеточной стенки
spbu.ru

medicine
medicine








